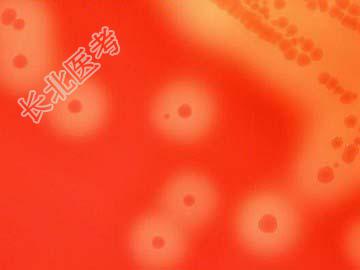

试题详情
- 单项选择题对于如图所示的在血琼脂平板上生长的菌落,以下描述正确的是 ( )
A、无溶血现象发生
B、有α溶血现象
C、有β溶血现象
D、既有α溶血也有β溶血现象
E、该细菌可能为牛链球菌
关注下方微信公众号,搜题查看答案

热门试题
- 关于黄病毒科的描述以下错误的是A、猪是流
- 志贺菌所致疾病中,下列哪一项不正确(
- 适合于培养霍乱弧菌的培养基是( )A
- 关于流感嗜血杆菌,叙述正确的是A、可在呼
- 可用于制备疫苗的结核分枝杆菌的变异是
- 流行性乙型脑炎病毒的传播媒介是A、硬蜱B
- 在分类上沙眼衣原体属于A、真菌B、病毒C
- 巨细胞病毒不可能潜伏在( )A、乳腺B
- 链球菌感染引起的变态反应疾病包括A、Ⅰ型
- 碳源和氮源利用试验不包括 ( )A、马尿
- 对酸敏感的细菌有 ( )A、霍乱
- 关于肠道杆菌O抗原的叙述中正确的是 (
- 正链RNA病毒的核酸特点是( )A、自
- 铜绿假单胞菌的生物学形状是 (
- 除了HBV感染,哪种病毒可增加原发性肝癌
- 如图所示真菌孢子的描述中正确的是 ( )
- 引起自然疫源性烈性传染病的病原菌是 (
- 不符合钩端螺旋体的培养性状的是 ( )A
- 关于低温保存细菌正确的是 ( )
- 根据O抗原,志贺菌属分为多个群,其中D群